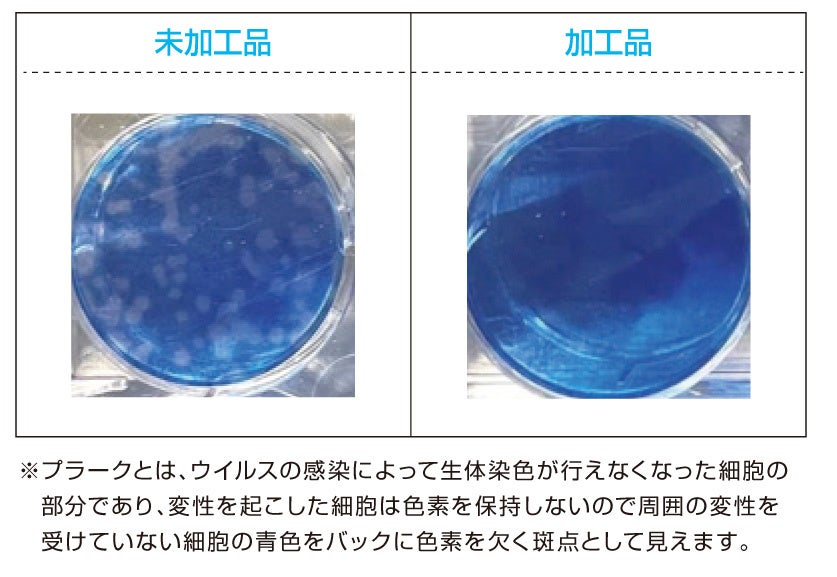

業界初 タイルカーペットで3つのSEKマークを取得 抗菌防臭加工・制菌加工・抗ウイルス加工
特定のウイルスの数を減少させるタイルカーペットの開発に成功
株式会社川島織物セルコン(本社:京都市左京区 社長:木村弘一)は、抗菌防臭加工・制菌加工・抗ウイルス加工の3種のSEKマークを取得した業界初のタイルカーペットを開発、2022年2月1日より発売します。
新型コロナウイルスの発生以来、安心・安全への関心が高まっています。インテリアに対する需要も同様で、特に抗菌・抗ウイルス仕様へのニーズが増加しています。今般、川島織物セルコンは抗菌・抗ウイルス加工を施したタイルカーペットの開発に成功、製品化を決定しました。

タイルカーペットは、土足歩行が多くとても汚れやすい環境で使用されることが多い製品です。このタイルカーペットは、カーペットの土台となる基布部分に抗菌・抗ウイルス加工、表面を彩るパイル部分に防汚加工を施し、カーペットに付着した細菌やウイルスを減らす効果と、汚れを付きにくくする効果の両面から床を美しく保つことを目指しました。
また、一般社団法人繊維評価技術協議会が設けたSEKマーク繊維製品認証基準に合格、合格した商品だけが表示できる「SEKマーク」のうち抗菌防臭加工・制菌加工・抗ウイルス加工の3種を取得しました。3種のマークを取得しているタイルカーペットは、業界で当製品のみです。
川島織物セルコンは、これからも、時代のニーズに即した高機能商材の研究開発に積極的に取り組んでいきます。

| 商品名 | シチリアレザー(1柄2アイテム) |
| 品番 | AB430-1、AB430-2 |
| 概要 | 基布部分に抗菌・抗ウイルス加工、 パイル部に防汚加工(SG加工)、 SEKマーク取得 |
| 収録シリーズ | MODE STYLE(モードスタイル) |
| 発売日 | 2022年2月1日 |
■抗菌・抗ウイルス加工タイルカーペット シチリアレザー 商品概要
繊維上の細菌の増殖を抑制し、特定のウイルスの数を減少させる加工を施したタイルカーペットです。
SEKマークの安全性基準に合格した抗菌・抗ウイルス加工剤を使用し、3つのSEKマークを取得しています。
SEKマーク3つの加工

| 抗菌防臭加工 | 制菌加工(一般用途) | 抗ウイルス加工 |
| 繊維上の細菌の増殖を抑制し、防臭効果を示す加工を施しています。 | 繊維上の細菌の増殖を抑制する加工を施しています。 | 繊維上の特定のウイルスの数を減少させる加工を施しています。 |

優れた抗菌・抗ウイルス性能

短時間で特定のウイルスの数を減少
未加工品と抗ウイルス加工品にそれぞれ特定のウイルスを接種し、25℃で2時間後に特定ウイルスの数を測定した結果99.99%以上減少していたことが確認されました。
※注意
- 抗ウイルス加工は、病気の治療や予防を目的とするものではありません。
- 抗ウイルス性試験は、ウイルス株:ATCC VR -1679(エンベロープ有) を25℃で2時間放置して実施しています。
- 抗ウイルス加工は、ウイルスの働きを抑制するものではありません。
このプレスリリースには、メディア関係者向けの情報があります
メディアユーザーログイン既に登録済みの方はこちら
メディアユーザー登録を行うと、企業担当者の連絡先や、イベント・記者会見の情報など様々な特記情報を閲覧できます。※内容はプレスリリースにより異なります。
すべての画像
